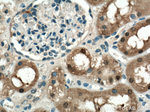
FN3K Antibody in Immunohistochemistry (Paraffin) (IHC (P))

Search
Proteintech
FN3K Polyclonal Antibody
{{$productOrderCtrl.translations['antibody.pdp.commerceCard.promotion.promotions']}}
{{$productOrderCtrl.translations['antibody.pdp.commerceCard.promotion.viewpromo']}}
{{$productOrderCtrl.translations['antibody.pdp.commerceCard.promotion.promocode']}}: {{promo.promoCode}} {{promo.promoTitle}} {{promo.promoDescription}}. {{$productOrderCtrl.translations['antibody.pdp.commerceCard.promotion.learnmore']}}
产品信息
14293-1-AP
种属反应
宿主/亚型
分类
类型
抗原
偶联物
形式
浓度
规格
纯化类型
保存液
内含物
保存条件
运输条件
产品详细信息
Immunogen sequence: MEQLLRAEL RTATLRAFGG PGAGCISEGR AYDTDAGPVF VKVNRRTQAR QMFEGEVASL EALRSTGLVR VPRPMKVIDL PGGGAAFVME HLKMKSLSSQ ASKLGEQMAD LHLYNQKLRE KLKEEENTVG RRGEGAEPQY VDKFGFHTVT CCGFIPQVNE WQDDWPTFFA RHRLQAQLDL IEKDYADREA RELWSRLQVK IPDLFCGLEI VPALLHGDLW SGNVAEDDVG PIIYDPASFY GHSEFELAIA LMFGGFPRSF FTAYHRKIPK APGFDQRLLL YQLFNYLNHW NHFGREYRSP SLGTMRRLLK (1-309 aa encoded by BC042680)
靶标信息
FN3K catalyzes phosphorylation of fructosamines formed by glycation, the nonenzymatic reaction of glucose with primary amines followed by Amadori rearrangement. Phosphorylation of fructosamines may initiate metabolism of the modified amine and result in deglycation of glycated proteins.
仅用于科研。不用于诊断过程。未经明确授权不得转售。
篇参考文献 (0)
生物信息学
蛋白别名: Fructosamine-3-kinase; Protein-psicosamine 3-kinase FN3K; Protein-ribulosamine 3-kinase FN3K; unnamed protein product
基因别名: 2310074G21Rik; FN3K
UniProt ID: (Human) Q9H479, (Mouse) Q9ER35
Entrez Gene ID: (Human) 64122, (Mouse) 63828